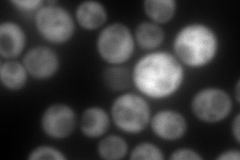
YMR169C
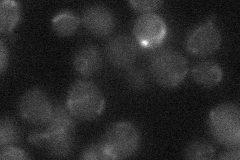
YMR169C
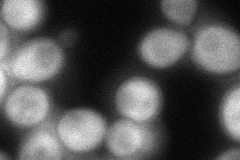
YMR169C

View description
Cytoplasmic aldehyde dehydrogenase, involved in beta-alanine synthesis; uses NAD+ as the preferred coenzyme; very similar to Ald2p; expression is induced by stress and repressed by glucose
Localization:
Intensity:
Fold change:
Significance:
-
C’ GFP library in SD

cytosol24.01 -
N' NOP1pr-GFP in SD

cytosol190.475 -
N' TEF2pr-mCherry in SD
cytosol334.694 -
N' NATIVEpr-GFP in SD
below threshold18.3493 -
N' TEF2pr-VC and Cyto-VN in SD
cytosol82.8988 -
C’ GFP library in SD+DTT

cytosol33.711.4Yes -
C’ GFP library in SD+H2O2

cytosol24.561.02No -
C’ GFP library in Starvation Media

cytosol49.972.08Yes -
C’ GFP library on the background of Pup2-DaMP

cytosol -
C’ GFP library on the background of CCT mutant

cytosol27.93191.16294No
